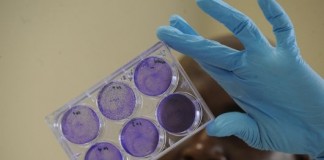

El extraño caso de la enana marrón desaparecida
El nuevo instrumento SPHERE muestra sus capacidades
El nuevo instrumento SPHERE, instalado en el Very Large Telescope de ESO, se ha utilizado para...
Las estrellas como el sol también explotan cuando mueren
IRAS 15103-5754, una nebulosa planetaria recién creada, aporta nuevas claves sobre la muerte de estrellas similares al Sol
El nacimiento de las nebulosas planetarias,...
Explorar los genomas para mejorar la sanidad animal
La FAO y el Instituto Suizo de Bioinformática (SIB) se asocian para desarrollar herramientas de tecnología punta para luchar contra la gripe aviar y...
Una asociación estelar condenada a la catástrofe
Se observa por primera vez el proceso de fusión de dos estrellas destinadas a convertirse en supernova
Utilizando las instalaciones de ESO, junto con...
“Let’s connect for a safe, empowering and inclusive Internet”
For Safer Internet Day Tuesday 10 February 2015 GENEVA (9 February 2015) – Top United Nations experts on children’s rights and on freedom...
March of the moons; Hubble captures rare triple moon transit of...
These new NASA/ESA Hubble Space Telescope images capture a rare occurrence as three of Jupiter’s largest moons parade across the giant gas planet’s banded...
Fundación Repsol organiza el Foro de innovación del Fondo de Emprendedores
La sede de Fundación Repsol en Madrid ha acogido el Foro de innovación del Fondo de Emprendedores, especializado en el sector de la ingeniería.El...
El Observatorio Virtual Español: diez años de «Big Data» astronómico
El Centro de Astrobiología a la vanguardia internacional en la explotación científica de los archivos de datos astronómicos.
Los archivos astronómicos constituyen una infraestructura...
VISTA mirando a través de la Vía Láctea
Esta nueva imagen infrarroja de la nebulosa Trífida revela la existencia de nuevas estrellas variables al fondo
Una nueva imagen, tomada con el telescopio...
Alianzas innovadoras para el acceso a agua y saneamiento. Servicios equitativos...
Ver otros estudios de caso
Descarga el informe en PDF
KwaZulu-Natal es, de las nueve provincias de Sudáfrica, la segunda más grande con...
Creando espacios para innovar. El caso de la Unidad de agua...
Por Tracey Keatman, miembro del itdUPM y del Building Partnerships for Development in Water and Sanitation -BPD-. (See this post in English)
“Innovar sale de...
Revolucionarias imágenes de ALMA revelan una génesis planetaria
Esta nueva imagen de ALMA, el Atacama Large Millimeter/submillimeter Array, revela detalles extraordinarios que nunca antes se habían visto en un disco de formación...
El Lehendakari Iñigo Urkullo inaugura la XIV Semana de la Ciencia,...
Euskadi renueva su compromiso con la ciencia, tecnología e innovación
· El Lehendakari ha destacado que “la innovación es un reto de...
El VLTI detecta luz exozodiacal
Nuevo reto para detectar exotierras con imagen directa
Utilizando toda la capacidad del VLTI (Very Large Telescope Interferometer), un equipo internacional de astrónomos ha...
Polonia se une al Observatorio Europeo Austral
En la jornada de hoy, Lena Kolarska-Bobińska, Ministra de Ciencia y Educación Superior de Polonia, firmaba un acuerdo cuyo objetivo final es que este...
Descubierto un “salvavidas” para la formación de planetas en un sistema...
ALMA examina una rueda de polvo y gas dentro de otra rueda de la misma composición
Utilizando ALMA, los astrónomos han detectado, por...
Energía solar en los árboles
La empresa israelí Sologic ha presentado su árbol solar: un espacio centrado en un árbol artificial que se carga con el sol y proporciona...
Izpisúa propone la creación de órganos humanos usando el cerdo
Tenerife acoge del 20 al 23 de octubre un encuentro formativo sobre su aplicación al cáncer
El investigador del Salk Institute (California, Estados Unidos)...
Los documentales científicos españoles continúan obteniendo el reconocimiento internacional
El premio Prismas está considerado el mayor galardón a la divulgación de la ciencia en España.
El jurado ha destacado “la gran calidad técnica...
Descubiertas dos familias de cometas alrededor de una estrella cercana
El instrumento HARPS, que se encuentra en el Observatorio La Silla de ESO, en Chile, se ha utilizado para hacer el censo más completo...
Probing the past
Using the NASA/ESA Hubble Space Telescope astronomers have made what may be the most reliable distance measurement yet of an object that existed in...
Nos preparamos para buscar huellas de vida en Marte
Un grupo de investigación del CAB forma de uno de los equipos seleccionados por el NASA Astrobiology Institute (NAI) en su nuevo programa para...
Los secretos de la construcción de una metrópoli galáctica
Un equipo de astrónomos ha utilizado el telescopio APEX para sondear un inmenso cúmulo de galaxias que se está formando en el universo primitivo,...
Hubble reveals most detailed exoplanet weather map ever
A team of scientists using the NASA/ESA Hubble Space Telescope have made the most detailed map ever of the temperature of an exoplanet’s atmosphere,...
Participación del CIEMAT en el MEDAMI 2014
Entre los días 3 y 7 de septiembre se celebró en Cerdeña el tercer workshop temático del mediterráneo sobre imagen molecular, MEDAMI (Mediterranean Thematic Workshops in...
San Sebastián acoge el mayor evento mundial sobre tecnologías de fusión
El Lehendakari, Íñigo Urkullu, presidirá el acto de inauguración del 28º Simposio sobre Tecnología de Fusión,SOFT 2014, que contará también con la presencia de...
Participación del CIEMAT en el 12th Pannonian Symposium on Catalysis
Recientemente ha tenido lugar en la República Checa, el 12th Pannonian Symposium on Catalysis (Simposio de Panonia en Catálisis), que ha reunido a los...
Reunión de los proyectos MetroNORM y MetroRWM en Praga
Los días 8 y 9 de septiembre de 2014 se celebró en la sede de SURO - National Radiation Protection Institute en Praga la reunión del...
Celebración en Soria del II Congreso Iberoamericano sobre microrredes con generación...
Soria acogerá del 6 al 8 de octubre el II Congreso Iberoamericano sobre Microrredes con generación distribuida de renovables (Aplicaciones prácticas de integración de...
Éxito de participación en el Infoday Industrial en el marco de...
Más de 150 asistentes se han dado cita hoy en el Infoday Industrial celebrado en el marco del vigésimo octavo Simposio sobre Tecnología de Fusión (SOFT)...